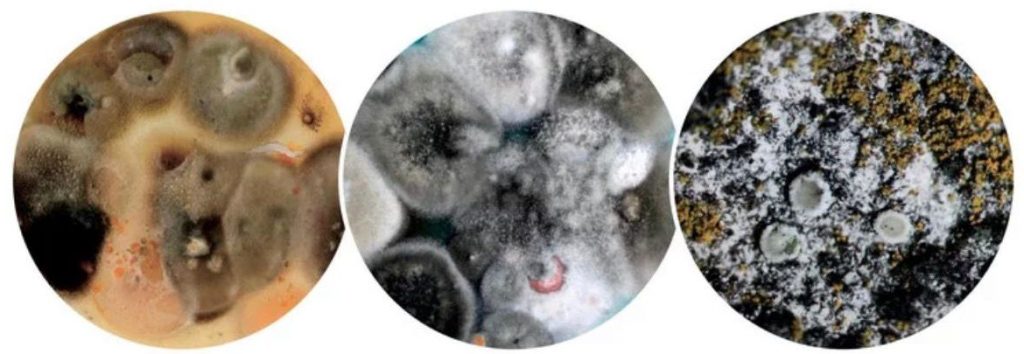

Nátěr fasád se zárukou 12 let





Nátěr fasád se zárukou 12 let: Technologie Caparol Clean Concept
Ve SchwarzPro věříme, že nátěr musí být víc než jen estetická úprava. Proto jsme certifikovaným partnerem programu Caparol Clean Concept, který jako jediný na trhu nabízí systémové řešení pro dlouhodobě čisté fasády se smluvní zárukou.
Proč je náš systém s Caparolem nejlepší volbou?
- Technologie NQG (Nano-křemenná mřížka): Používáme prémiové barvy (např. ThermoSan), kde nano-křemenné částice vytvářejí pevnou trojrozměrnou matrici. Ta chrání fasádu před znečištěním a zajišťuje, že povrch zůstává čistý a extrémně rychle vysychá po dešti i ranní rose.
- Aktivní boj proti biokorozi: Barva obsahuje zapouzdřené konzervační prostředky, které tvoří aktivní štít proti řasám a plísním. To není jen povrchová ochrana, ale hloubková prevence zdravotních rizik spojených s výskytem plísní u oken.
- Maximální prodyšnost a odolnost: Hybridní kombinace pojiv zajišťuje vysokou propustnost pro vodní páry (fasáda dýchá), ale zároveň je povrch vysoce odolný proti UV záření a povětrnostním vlivům.
Profesionální postup realizace:
- Hloubková sanace Caparol: Nejen mytí, ale kompletní zahubení řas a plísní pomocí speciálních biocidních roztoků.
- Technická příprava: Diagnostika stavu, oprava prasklin a vyspravení poškozených míst.
- Systémová penetrace: Použití originální penetrace pro sjednocení podkladu a maximální přilnavost barvy.
- Aplikace technologií Airless: Nanášení barvy moderní bezvduchovou technologií, která zajistí rovnoměrnou vrstvu i v hluboké struktuře omítky.
Uděláme vám nezávaznou nabídku!
Jak vzniká záruka 12 let?
Není to jen slib na papíře. Celý proces je přísně kontrolován:
- Dokumentace: Vedeme schválenou realizační dokumentaci.
- Kontrola výrobcem: Společnost Caparol kontroluje dodržení technologického postupu a spotřebu materiálů přímo na vaší stavbě.
- Společný záruční list: Po kontrole vystavuje Caparol a SchwarzPro oficiální záruční list na 12 let.
Nejsou to jen čísla
Naši práci vykonáváme od roku 2021 a za tu dobu jsme nabrali mnohem víc než jen spoustu bohatých zkušeností. Zůstalo po nás mnoho kvalitní práce za poctivou cenu a spoustu spokojených klientů.
Let na trhu
Spokojených klientů

Skvěle a rychle odvedená práce. Jsou to profesionálové, dokonale uklizeno, cena rozumná. Děkuji a s radostí doporučuji.

Děkujeme za perfektní odvedenou práci. Děláte své profesi opravdu čest. Proto doporučuji vaši práci i dalším zájemcům.

Kluci pracovití, práce profesionálně odvedena. Na čem jsme se domluvili, to bylo do puntíku splněno. Oceňuji i přístup a komunikaci šéfa.
Těším se na další spolupráci!


